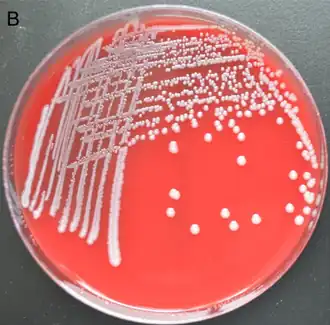
Description de cette image, également commentée ci-après

Klebsiella terrigena
| Domaine | Bacteria |
|---|---|
| Embranchement | Proteobacteria |
| Classe | Gammaproteobacteria |
| Ordre | Enterobacteriales |
| Famille | Enterobacteriaceae |
| Genre | Klebsiella |
Klebsiella terrigena est une espèce bactérienne à Gram négatif du genre Klebsiella.
Description
Les bactéries de l'espèce K. terrigena sont des bacilles Gram négatif, anaérobies facultatives, non mobiles et ne sporulant pas. Leur largeur est de 0,3 µm à 1,5 µm pour une longueur de 0,6 µm à 6 µm. Elles sont capables de croître sur gélose à 30 °C et 37 °C. Contrairement à Klebsiella pneumoniae et K. oxytoca, elles sont capables de croître à 4 °C mais pas à 41 °C[2]. Ces bactéries sont positives au test Voges-Proskauer. Elles sont capables de produire de l'histamine contrairement aux bactéries des complexes K. pneumoniae et K. oxytoca[3].
Nomenclature et taxonomie
Initialement décrite comme bactérie du genre Klebsiella, cette espèce a reçu l'épithète terrigena (ter.ri.ge'na. L.n. terra qui veut dire sol; L. suffixe gena signifiant origine) pour évoquer le lieu d'isolement initial d'une partie des souches étudiées dans l'article de description[2]. La souche type de cette espèce est la souche 84[4] isolée d'eau potable[2]. Elle est déposée dans les principales collections de cultures bactériennes sous les numéros ATCC 33257, CIP 80.07, DSM 2687 et NCTC 13038[2],[5].
Des comparaisons phylogéniques entre les gènes codant l'ARNr 16s et rpoB de cette espèce et ceux d'autres espèces de Klebsiella ont suggéré une classification dans un nouveau genre, Raoultella[6]. Un temps adoptée, des études phylogénétiques plus robustes ont montré dès 2014 que l'ancien genre Raoultella était niché au sein des Klebsiella et devait donc être abandonné.
Habitat
Elle a principalement été isolée à partir d'échantillons de sols non pollués et d'eaux de surface ou buvables[2], mais rarement chez l'homme. Des études ont estimé que moins de 1% des personnes en bonne santé hébergent cette espèce[7].
Pathogénie
Peu après sa description, il a été montré que cette espèce possède de nombreux facteurs de virulence exprimés par d'autres espèces de Klebsiella telles que Klebsiella pneumoniae, cependant il n'était pas prouvé que K. terrigena soit responsable de maladie chez l'homme[8].
En culture, il a été démontré que R. terrigena convertit directement la mélamine en acide cyanurique. Les rats colonisés par R. terrigena ont développé des dommages rénaux induits par la mélamine plus importants que ceux non colonisés[9]. Raoultella terrigena est soupçonnée d'être un facteur potentiel de toxicité de la mélamine chez l'humain par extrapolation des résultats en culture, et de sa présence dans la flore buccale chez l'homme[9].
Depuis la découverte de ses gènes de virulence, Raoultella terrigena a été reconnue responsable de différentes affections chez l'homme comme des abcès sous-unguéaux[1], des pneumonies, des endocardites infectieuses, des bactériémies et septicémies[10]. Une revue de la littérature portant sur 363 cas d'infections dues à R. terrigena a montré une mortalité s'élevant à environ 44 % des cas, souvent liée à son profil de bactérie multi-résistante[10].
Références
- 1 2 Yu Wang, Xiawei Jiang, Zemin Xu, Chaoqun Ying, Wei Yu et Yonghong Xiao, « Identification of Raoultella terrigena as a Rare Causative Agent of Subungual Abscess Based on 16S rRNA and Housekeeping Gene Sequencing », Canadian Journal of Infectious Diseases and Medical Microbiology, vol. 2016, (DOI 10.1155/2016/3879635)
- 1 2 3 4 5 6 Izard, Ferragut, Gavini, Kersters, De Ley et Leclerc, « Klebsiella terrigena, a new species from soil and water », International Journal of Systematic Bacteriology, vol. 31, no 2, , p. 116–127 (DOI 10.1099/00207713-31-2-116)
- ↑ Tobias M. Appel, Natalia Quijano-Martínez, Elsa De La Cadena, María F. Mojica et María Virginia Villegas, « Microbiological and Clinical Aspects of Raoultella spp. », Fontriers in Public Health, (DOI 10.3389/fpubh.2021.686789)
- ↑ Dans l'article de description, elle porte les numéros L 84 et CUETM 77-176
- ↑ (en) « Species Raoultella terrigena » [archive du ], sur List of Prokaryotic names with Standing in Nomenclature (consulté le )
- ↑ Drancourt, Bollet, C, Carta, A et Rousselier, P, « Phylogenetic analyses of Klebsiella species delineate Klebsiella and Raoultella gen. nov., with description of Raoultella ornithinolytica comb. nov., Raoultella terrigena comb. nov. and Raoultella planticola comb. nov. », International Journal of Systematic and Evolutionary Microbiology, vol. 51, no Pt 3, , p. 925–32 (PMID 11411716, DOI 10.1099/00207713-51-3-925)
- ↑ Neergaard, « Study Examines Why Most Survived China’s Melamine Scare », Food Manufacturing News, Food Manufacturing (consulté le )
- ↑ Podschun, Fischer et Ullmann, « Characterization of Klebsiella terrigena strains from humans: haemagglutinins, serum resistance, siderophore synthesis, and serotypes », Epidemiol Infect, vol. 125, no 1, , p. 71–8 (PMID 11057961, PMCID 2869571, DOI 10.1017/S0950268899004124)
- 1 2 Xiaojiao Zheng, Aihua Zhao, Guoxiang Xie, Yi Chi, Linjing Zhao, Houkai Li, Congrong Wang, Yuqian Bao, Weiping Jia, Mike Luther, Mingming Su, Jeremy K. Nicholson et Wei Jia, « Melamine-induced renal toxicity is mediated by the gut microbiota », Science Translational Medicine, vol. 5, no 172, , p. 172ra22 (PMID 23408055, DOI 10.1126/scitranslmed.3005114)
- 1 2 Nadiia Lekhniuk, Ulbolgan Fesenko, Yaroslav Pidhirnyi, Alicja Sękowska, Olena Korniychuk et Yulian Konechnyi, « Raoultella terrigena: Current state of knowledge, after two recently identified clinical cases in Eastern Europe », Clinical Case Reports, vol. 9, no 5, , e04089 (DOI 10.1002/ccr3.4089)
Bibliographie
- Don J. Brenner, Noel R. Krieg, James T. Staley, George M. Garrity, David R. Boone, Paul De Vos, Michael Goodfellow, Fred A. Rainey et Karl-Heinz Schleifer, Bergey's Manual of Systematic Bacteriology, vol. 2 : The Proteobacteria Part A Introductory Essays, Boston, Springer, , 304 p. (ISBN 9780387241432)
- Don J. Brenner, Noel R. Krieg, James T. Staley, George M. Garrity, David R. Boone, Paul De Vos, Michael Goodfellow, Fred A. Rainey et Karl-Heinz Schleifer, Bergey's Manual of Systematic Bacteriology, vol. 2 : Part B The Gammaproteobacteria, Boston, Springer, , 304 p. (ISBN 9780387280226)
- George M. Garrity (éditeur en chef), Timothy G. Lilburn, James R. Cole, Scott H. Harrison, Jean Euzéby et Brian J. Tindall, « Part 5 - The Bacteria: Phylum Proteobacteria, Class Gammaproteobacteria », dans Taxonomic Outline of Bacteria and Archaea, vol. 7, Michigan State University & NamesforLife, , 628 p. (lire en ligne [PDF]), p. 148-245
- Portail de la microbiologie
- Portail de la médecine